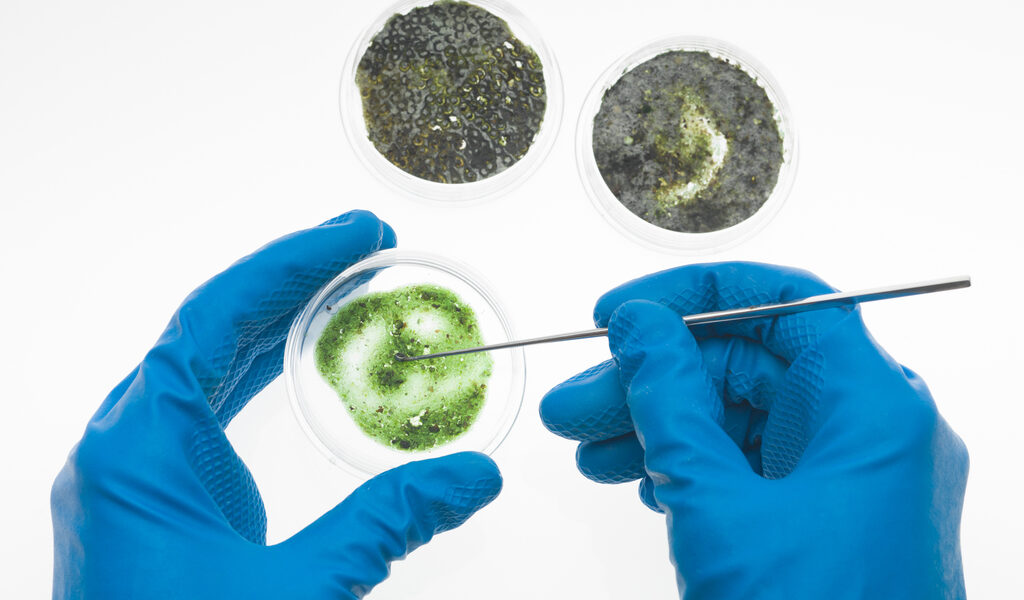

How Much Does a Mold Testing Cost in Toronto?
In the vibrant yet humid city of Toronto, where seasonal shifts from sweltering summers to icy winters create the perfect breeding ground for unwanted guests like mold, homeowners and property managers are increasingly turning to professional mold testing to safeguard their health and homes. If you’ve noticed a musty odor in your basement, unexplained allergies flaring up, or mysterious water stains on your walls, you’re not alone. At Mold Assist, we understand the urgency of addressing these concerns promptly. As experts in mold inspection in Toronto, we’re here to demystify the cost of mold testing in Toronto, helping you navigate pricing, processes, and why this investment is crucial for your well-being.
This comprehensive guide, updated for 2025, dives deep into the average mold testing costs in Toronto, explores the factors that influence pricing, and outlines what a thorough mold inspection report entails. Whether you’re a first-time buyer in the GTA, a landlord in downtown Toronto, or a business owner in Mississauga, understanding these details empowers you to make informed choices. By the end, you’ll know exactly what to expect and how mold testing services in Toronto can prevent costly remediations down the line. Let’s get started on creating a healthier indoor environment.
What is Mold Testing and Why Do You Need It in Toronto?
Mold testing, also known as mold inspection, is a systematic process to detect, identify, and quantify mold growth in indoor environments. Unlike a simple visual check, professional mold testing in Toronto involves advanced techniques to uncover hidden spores that could compromise your air quality. Mold thrives in damp, poorly ventilated spaces—conditions all too common in Toronto’s climate, with average humidity levels hovering around 50-60% in summer and condensation issues plaguing basements during winter.
At its core, mold inspection includes:
- Visual Assessment: Inspectors examine visible signs like discoloration, water damage, or efflorescence on walls, ceilings, and floors.
- Moisture Detection: Using tools like moisture meters and thermal imaging cameras to identify hidden leaks or high humidity pockets.
- Air Sampling: Collecting airborne spores to measure concentration and types of mold (e.g., Aspergillus, Stachybotrys, or the infamous “black mold”).
- Surface Sampling: Swabs, tape lifts, or bulk samples from suspect materials like drywall or carpet for lab analysis.
- Environmental Readings: Assessing temperature, humidity, and ventilation to determine growth conditions.
In Toronto, where heavy rainfall (about 800mm annually) and lake-effect humidity exacerbate issues, mold testing isn’t just precautionary—it’s essential. According to Health Canada, indoor mold can be 2-5 times more concentrated than outdoor levels, leading to respiratory problems, allergies, and structural damage if ignored. Early detection through professional mold testing can save thousands in remediation costs and protect vulnerable family members, like children or the elderly, from exposure.
At Mold Assist, our certified inspectors use IICRC-compliant methods to ensure accurate results, tailored to Toronto’s unique challenges like aging Victorian homes in Cabbagetown or high-rise condos in Yonge-Eglinton.
The Importance of Mold Testing in Toronto’s Humid Climate
Toronto’s weather is a mold enthusiast’s dream: humid summers foster spore proliferation, while winter snowmelt and poor insulation trap moisture indoors. The city’s proximity to Lake Ontario amplifies this, with relative humidity often exceeding 70% during peak seasons, creating ideal conditions (above 60% humidity and temperatures over 20°C) for mold to flourish in just 24-48 hours after water exposure.
Why is mold testing critical here? First, health risks: Inhaling mold spores can trigger asthma attacks, sinus infections, and skin irritations. A 2025 study by the Canadian Lung Association highlights that urban dwellers in humid regions like the GTA face a 30% higher risk of mold-related illnesses. Second, property damage: Untreated mold erodes drywall, wood, and insulation, leading to weakened structures and skyrocketing repair bills—averaging $5,000-$30,000 for severe cases.
For real estate transactions, a clean mold inspection report is a game-changer. Sellers in competitive markets like Leslieville avoid deal-breakers, while buyers negotiate better terms. Businesses in commercial hubs like the Financial District must comply with Ontario’s Occupational Health and Safety Act, mandating safe air quality.
Proactive mold testing in Toronto also ties into broader indoor air quality (IAQ) management. With residents spending 90% of time indoors, undetected mold can exacerbate poor ventilation in energy-efficient homes, amplifying VOCs and allergens. At Mold Assist, we emphasize prevention: Regular testing post-flooding (common after Toronto’s spring thaws) or renovations keeps your space mold-free.
Common hotspots in Toronto homes include basements (60% of cases), attics, and HVAC systems—areas our inspections target meticulously.
Key Factors Influencing Mold Testing Costs in Toronto
The cost of mold testing in Toronto varies based on several variables, ensuring you pay for services that match your property’s needs. No two assessments are identical, and understanding these factors helps avoid surprises.
- Property Size and Layout: Larger homes or multi-unit buildings require more time and samples. A condo under 1,000 sq ft might cost less than a detached house in Scarborough over 2,500 sq ft.
- Type and Scope of Testing: Basic visual inspections are cheaper than comprehensive air/surface sampling. Lab analysis for toxic molds like Stachybotrys adds fees.
- Number of Samples: Each air sample ($80-$120) or swab ($50-$100) increases costs. Multi-room testing for widespread concerns multiplies this.
- Location and Accessibility: Downtown Toronto might incur travel fees for GTA outskirts like Vaughan, while hard-to-reach attics or crawlspaces demand extra effort.
- Urgency and Timing: Rush jobs post-flood can add 20-30% premiums, while off-season (winter) bookings may offer discounts.
- Inspector Expertise and Certifications: IICRC or NORMI-certified pros charge more for reliable, compliant work—worth it to avoid redo costs.
- Additional Services: Bundling with IAQ readings or remediation quotes can adjust totals. Free inspections from some firms (if visible mold) offset upfront expenses.
Lab fees ($250 average) and report complexity also play roles. In Toronto’s competitive market, expect 10-15% annual inflation, but transparent providers like Mold Assist offer fixed quotes.
Average Costs for Mold Testing in Toronto (2025 Update)
Drawing from 2025 market data, mold testing costs in Toronto range from $250 to $800 for most residential properties, with commercial assessments higher. These include on-site work, sampling, and basic reporting—lab fees extra.
- Basic Visual Inspection: $250-$400 for small homes/condos, covering moisture checks and initial assessment. Often free with remediation commitment.
- Standard Mold Testing Package: $350-$550 for up to 2,000 sq ft, including 2-3 air/surface samples and humidity readings.
- Comprehensive Inspection with Lab Analysis: $450-$650, ideal for larger homes or suspected toxic mold, adding spore identification.
- Commercial Testing: $600-$1,200+, factoring in business downtime and compliance.
- Per-Sample Add-ons: Air ($80-$150), Surface ($50-$100).
At Mold Assist, our entry package starts at $499, with no hidden fees and free quotes for GTA clients. DIY kits ($20-$100) tempt but lack accuracy—professionals ensure lab-verified results.
Here’s a quick cost breakdown table for clarity:
| Service Type | Average Cost (CAD) | What’s Included |
|---|---|---|
| Visual Only | $250-$400 | Inspection, moisture readings |
| Basic Sampling | $350-$450 | 1-2 samples, initial report |
| Full Testing | $450-$650 | Multiple samples, lab analysis, detailed report |
| Add’l Sample | $50-$150 | Per extra air/surface test |
These reflect GTA averages; shop around for value.
What Does a Professional Mold Inspection Report Include?
A quality mold inspection report is your roadmap to resolution—detailed, actionable, and compliant with Health Canada standards. Delivered within 3-7 days, it typically spans 10-20 pages and includes:
- Executive Summary: High-level findings, risk levels (low/medium/high), and urgency recommendations.
- Visual and Site Notes: Photos of affected areas, moisture maps from thermal scans, and environmental data (e.g., 65% humidity in basement).
- Lab Results: Spore counts, mold types (e.g., 500 spores/m³ Cladosporium), and comparisons to outdoor baselines. Includes chain-of-custody for credibility.
- Analysis and Interpretation: Explanations of results (e.g., elevated Stachybotrys indicates water damage) and health implications.
- Recommendations: Step-by-step remediation plan, from DIY fixes to pro removal, plus prevention tips like dehumidifiers.
- Appendices: Raw data, certifications, and disclaimers.
For example:
| Sample Type | Location | Spore Count (per m³) | Mold Types Detected | Status |
|---|---|---|---|---|
| Air | Living Room | 300 | Aspergillus, Penicillium | Normal |
| Surface Swab | Basement Wall | 1,200 | Stachybotrys | Elevated – Remediate |
| Outdoor Control | Exterior | 250 | Mixed | Baseline |
This format ensures clarity for non-experts. At Mold Assist, reports are user-friendly, with digital access and follow-up consultations.
Choosing the Best Mold Testing Provider in Toronto
With dozens of options, select wisely:
- Certifications: IICRC, IAQA, or NORMI ensure expertise.
- Local Experience: GTA-savvy firms handle Toronto-specific issues like condo leaks.
- Reviews: Check HomeStars or Google for 4.5+ stars .
- Full Services: Inspection-to-remediation for seamless support.
Avoid unregulated “inspectors”—Ontario lacks licensing, so vet credentials. Mold Assist stands out with 10+ years in Toronto, unbiased testing, and eco-friendly methods.
DIY vs. Professional Mold Testing: What’s the Verdict?
DIY kits are affordable but unreliable—false positives from contaminated petri dishes skew results. Pros offer precision, liability coverage, and legal reports for insurance claims. For Toronto’s complex homes, professional mold testing is indispensable.
Test annually or post-water events for maintenance.
Long-Term Benefits of Investing in Mold Testing
Beyond costs, mold testing boosts property value (up 5-10% with clean reports), cuts energy bills via better ventilation, and enhances health—reducing sick days by 20% per studies. In Toronto’s rising market, it’s a proactive edge.
Conclusion
The cost of mold testing in Toronto averages $499-$650 in 2025, varying by scope and size, but delivers invaluable peace of mind. Don’t let hidden spores compromise your sanctuary—invest today for a healthier tomorrow.
Contact Mold Assist for a consultation. Breathe easy in Toronto!
